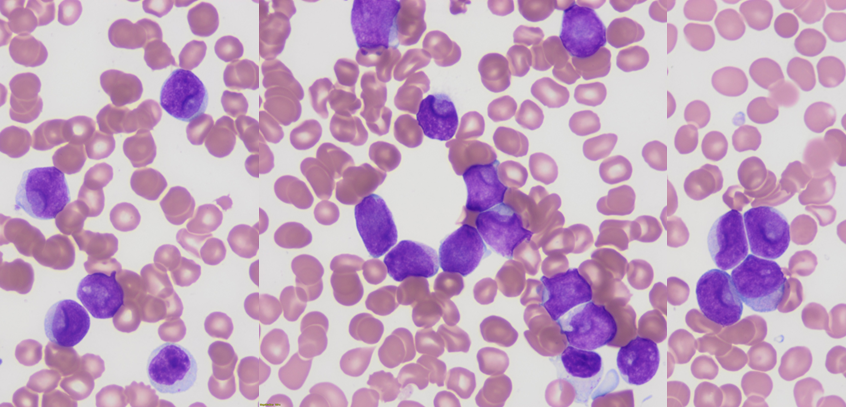
One of those leukemias that read the books.. a perfect example of Cup-like blasts... flow phenotype was CD34-, CD117+, HLA-DR- , which often raises concern for APL... This is a classic example of NPM1-mutated AML..  #hemepath #leusm 

pubmed.ncbi.nlm.nih.gov/19672946/

U of Cincinnati MLS
@uofcincymls
University of Cincinnati Medical Laboratory Science (MLS) Program
ID: 839904548399509509
http://www.cahs.uc.edu/ClinicalHealthInformationSciences/academics/bs-in-medical-laboratory-science 09-03-2017 18:23:43
329 Tweet
169 Takipçi
197 Takip Edilen